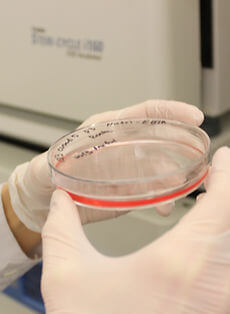

Deliverables, Objectives and Products
Multiple Sclerosis

Alzheimer's Disease

Guillain-Barré Syndrome Treatment

Chronic Septic Granulomatosis disease





